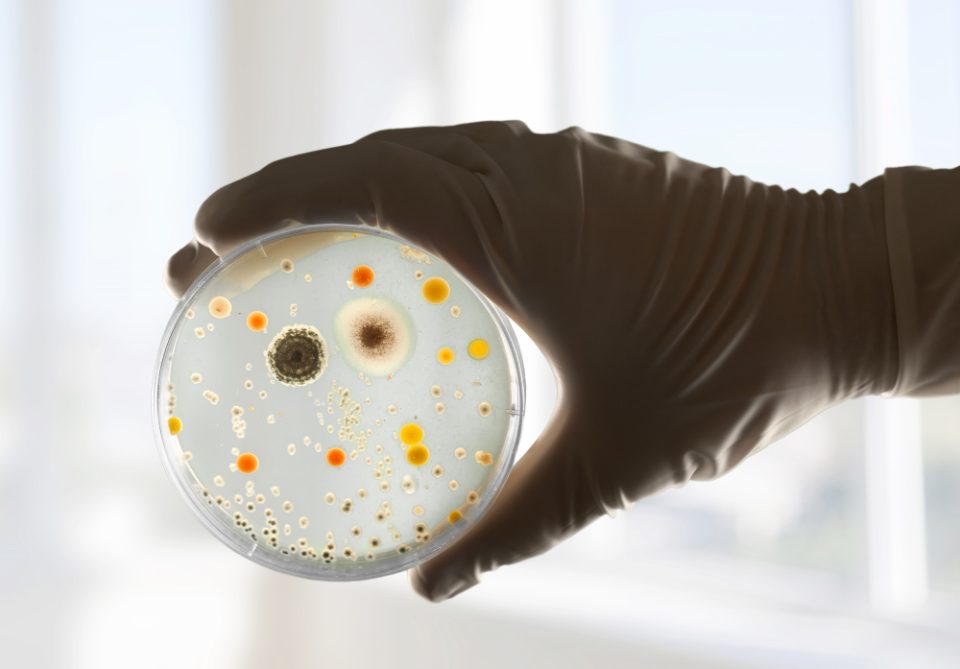
Oтпорни се на 10 антибиотици: Бактерии стари 5.000 години се најдени во мраз во Романија

Сој бактерии стар 5.000 години е пронајден во мраз во пештера во Романија, и тој покажува отпорност на 10 современи антибиотици, според ново истражување објавено во научното списание „Фронтиерс ин мајкробиолоџи“ (Frontiers in Microbiology). Според научниците, ова откритие би можело да помогне во разбирањето на ширењето на антимикробната отпорност, но и во развојот на нови терапии. Истражувањето го испитувало сојот „Сајкробактер СЦ65А.3“ (Psychrobacter SC65A.3), изолиран од слој прастар мраз во една од најголемите подземни ледени пештери во Европа.
Авторката на истражувањето, микробиологот Кристина Пуркареа од Институтот за биологија во Букурешт, при Романската академија, изјави дека овој сој, и покрај своето потекло, носи повеќе од 100 гени поврзани со отпорноста кон современите антибиотици, пренесува научниот портал „Попсај“ (PopSci).
– Тие 10 антибиотици кај коишто откривме отпорност се широко користени во орални и инјекциски терапии за лекување сериозни бактериски инфекции, вклучително и туберкулоза, колитис и болестите на уринарниот тракт, изјави Пуркареа.
Научниците, во оваа прилика предупредуваат дека топењето на мразот поради климатските промени може да ослободи прастари микроорганизми и нивните гени за отпорност, коишто потоа би можеле да се пренесат на современите бактерии и дополнително да ја усложнат денешната борба против болестите на совремието. Истражувачкиот тим издупчил дупка во мразот длабока 25 метри, а ледениот блок има волумен од околу 100.000 кубни метри. Мразот е стар приближно 13.000 години, што го прави еден од најголемите и најстарите подземни ледени блокови.
„Но, овие микроорганизми произведуваат уникатни ензими и антимикробни соединенија коишто би можеле да послужат како основа за развој на нови антибиотици и биотехнолошки иновации. Геномот на ‘Сајкробактер СЦ65А.3’ има речиси 600 гени со непознати функции што би можеле да содржат индиции за третман на други болести, а исто така, постојат 11 гени коишто би можеле да убијат или да го запрат растот на други бактерии, габи и вируси“, истакнуваат истражувачите во својот напис.
Анализата на примероците изолираше различни соеви на бактерии, а секвенционирањето на геномот утврди кои гени овозможуваат преживување на ниски температури, како и оние кои придонесуваат за антимикробната отпорност.
– Проучувањето на микробите од ледените наслаги од пред илјадници години, покажува дека отпорноста на антибиотици се развила природно во животната средина долго пред да почнат да се користат модерните антибиотици. Но, потребна е посебна претпазливост при работа со вакви примероци за да се спречи неконтролирано ширење, додаде Пуркареа.
Според Светската здравствена организација (СЗО), антимикробната отпорност е еден од водечките глобални здравствени проблеми и се проценува дека е одговорна за милиони смртни случаи годишно. Во Европа, според Европскиот центар за превенција и контрола на болести (ЕЦДЦ), повеќе од 35.000 луѓе годишно умираат од болести предизвикани од бактерии отпорни на антибиотици.